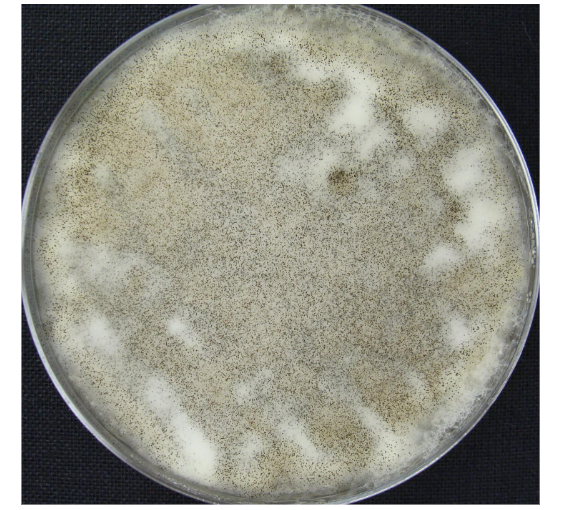
knowt flashcard image
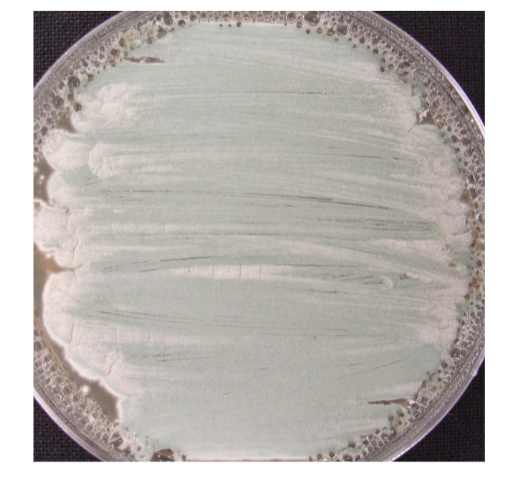
knowt flashcard image

1/52
Looks like no tags are added yet.
Name | Mastery | Learn | Test | Matching | Spaced | Call with Kai |
|---|
No analytics yet
Send a link to your students to track their progress
viruses (def)
not considered to be alive
cannot reproduce without a host cell
cause many diseases in plants and animals
bacteriophage (picture)

genetic material types
DNA and RNA
capsid
protein covering that encloses and transports genetic material
bacteriophage
complex; DNA virus
polyhedral head, sheath, tail fibers, tail pins
infect bacteria on plant leaves- dont cause disease
helical virus (picture)

helical virus definition
rod shaped; capsid proteins and rna
ex) tobacco mosaic virus
causes infection in 9 plant families- 300+ species
mosaic discoloration in leaves- yellowing
horizontal gene transfer- tools, chewing insects, touching
most transmissible virus- virus on fingers after handling tobacco
adenovirus (picture)

adenovirus definition
polyhedral capsid- 20 sided; receptors
most common capsid type in plant viruses
rembrandt helical virus
virus disrupts pigment genes in tulip flowers
cultivated as color patterns in flowers
virus eventually kills plant
asexual propagation- horizontal gene transfer
viroid infections in plant (examples)
potato spindle tumor viroid
cadang cadang
avocado sunblotch viroid
bacteria colony morphology

prochloron
oxygenic
most chloroplast like cyanobacterium

oscillatoria

nostoc

anabaena

rhizobium bacteria
mutualistic with legumes
forms root nodules- fixes atmospheric nitrogen; N2
pseudomonas
bacteria infection
leaf spotting- Hibiscus and soybeans
bacteriophages used to control bacteria diseases in plants
bacteria host specific bacteriophages kill Pseudomonas
mycoplasma
bacteria infection
Mycoplasma transferred horizontally- saliva of sucking insects
crop and horticultural plants
sugarcane, cherries, peaches, cone flower, cannabis
yellowing, small and shriveled fruit
erwinia
bacteria infection
fire blight disease in apples
hyphae
filamentous growth form in fungi
mycelium
mass of filaments
rhizopus
black bread mold; zygomycota

aspergillus
penicillium
mycorrhizae fungi
mutualistic with plant roots
endo (grows into root cells “arbuscular hyphae”) or ecto (in root between cells)
crustose lichen
flat on surface

foliose lichen
somwhat leaf like

fruticose lichen
more bushy and more branching; shrubby

asocarp
fungus reproductive structure in lichenn

soredia
produced by lichen for asexual reproduction

armillaria
conifer fungus parasite

euglena
unicellular protist
chloroplast, red eye spot, flagella, heterotrophic in dark
diatoms
diverse
Navicula; Stramenopiles
centric- radially symmetrical
pinnate- bilaterally symmetrical
brown algae
largest mulitcellular algae, stramenophile (SARS)
postelsia
multicellular brown algae; thallus
blade, stipe, holdfast- no air bladders

macrocystis
multicellular brown algae; kelp
blades, stipe, air bladders

fucus
multicellular brown algae
blades w/ recepticles containing conceptacle w/ antheridia and archegonia

sargassum
multicellular brown algae
blades, air bladders, stipe

ectocarpus
multicellular brown algae

dinoflagellate
SARS alveolate
2 flagella in grooves
groove perpendicular to midline of cell
groove parallel to midline of cell
ex) ceratium
Polysiphonia
archaeplastida, rhodophyta
red algae
3 multicellular forms in life cycle;
tetrasporophyte- diploid
gametophytes- haploid
carposporophyte- diploid
Chlamydomonas
archaeplastida, chlorophyta (green algae)
unicellular, motile green algae

closterium
archaeplastida, chlorophyta (green algae)
desmid; unicellular, non motile

micrasterias
archaeplastida, chlorophyta (green algae)
desmid; unicellular, non motile

scendesmus
archaeplastida, chlorophyta (green algae)
desmid; unicellular, non motile

gonium
archaeplastida, chlorophyta (green algae)
motile flat colony- 16 cells

pandorina
archaeplastida, chlorophyta (green algae)
hollow colony- 32 cells

volvox
archaeplastida, chlorophyta (green algae)
motile colonies

spirogyra
archaeplastida, chlorophyta (green algae)
non motile filament; spiral chloroplasts

oedogonium
archaeplastida, chlorophyta
unbranched filamentous green algae

hydrodictyon
archaeplastida, chlorphyta (green algae)
non motile filament, water net

ulva
archaeplastida, chlorphyta; green algae
multicellular sheet; sea lettuce